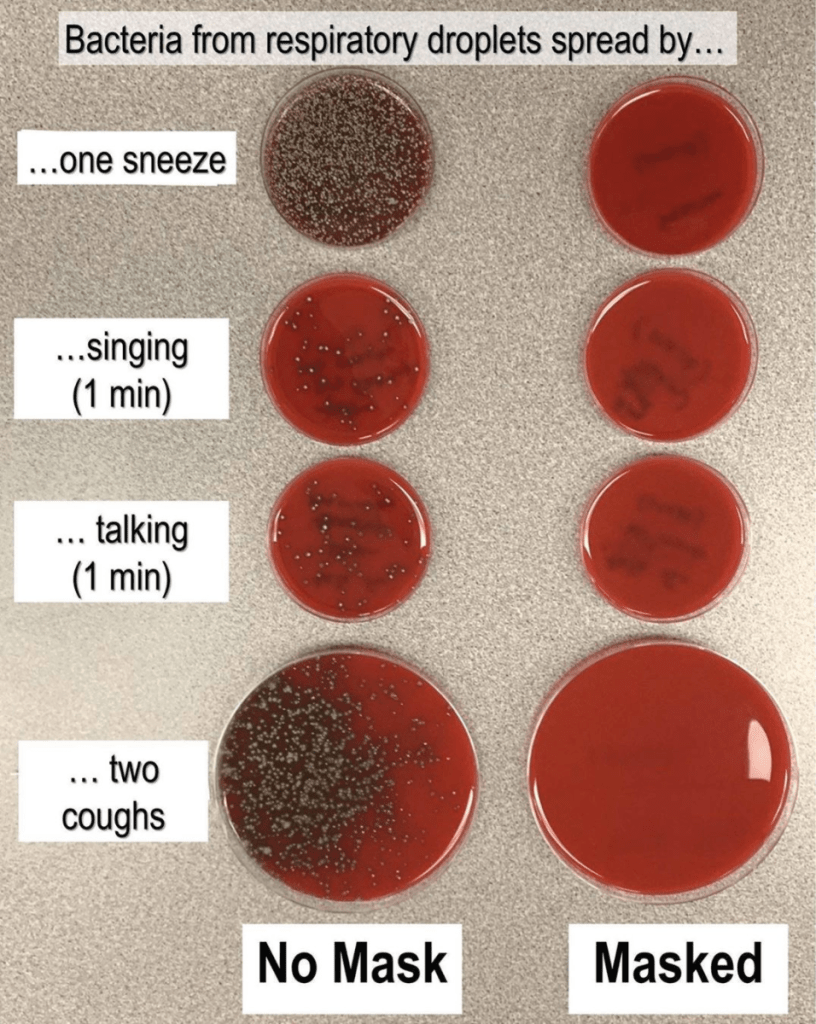

COVID-19 Mask Information
Wondering how best to use your mask? Here are some tips on how you can make a mask and when you may need to use it. A non-medical mask can be made using materials that you have in your home. They can be beneficial in settings where physical distancing is not possible.

Allyship
“Anti-racism is the active process of identifying and eliminating racism by changing systems, organizational structures, policies and practices and attitudes, so that power is redistributed and shared equitably.” – NAC International Perspectives: Women and Global Solidarity
Mask Importance
Wearing a homemade non-medical mask/facial covering in the community is recommended for periods of time when it is not possible to consistently maintain a 2-metre physical distance from others, particularly in crowded public settings, such as: stores, shopping areas, and public transportation.
Public health officials make recommendations based on a number of factors, including the rates of infection and/or transmission in the community. Wearing a mask alone will not prevent the spread of COVID-19. But as you can see from Dr. Richard Davis’s research, it has the potential to make a large difference. You must also consistently and strictly adhere to good hygiene and public health measures, including frequent hand washing and physical (social) distancing. Let’s continue to prevent the spread of the coronavirus. #Helpslowthespread #Covid19

Let’s stop demonizing mental illnesses this October. Let’s stop calling people struggling with mental issues “bipolar” or “OCD”. When we trivialize these issues, we throw them in the category of personality traits, to the realm of annoying quirks, without the possibility of change, rather than life altering issues that are highly treatable with proper help. Lastly, let’s educate ourselves and be more kind this spooky season.🧡

‘On the 11th hour, of the 11th day, of the 11th month, we will remember them.’ Today, we honour our brave Canadian soldiers who have served and continue to serve on behalf of our country. We pay tribute to their sacrifices and their services made for our freedom. #LestWeForget

Keeping Up With The Kurrent Events Series 3 – Crisis around the world🌏
After a controversial re-election, President Maduro was sworn into a second six-year term. Juan Guaidó was not in favour of this re-election and declared himself acting president on 23 January 2019. Venezuela’s economy has been drastically going down since Maduro’s first election, but the tension between the two leaders has caused greater conflicts. Hyperinflation and violence have become a huge problem and homicide rates continue to rise. Additionally, Venezuela continues to face food and medicine shortages and the majority of the country is now living in poverty, while millions of citizen have fled the country. #CrisisInVenezuela

Keeping Up With The Kurrent Events Pt. 2 – Humanitarians of the World
The Humanitarian Society of Vancouver would like to recognize Chief Theresa Kachnidamato for her extraordinary humanitarian work, such as creating the initiative to stop child marriages in Malawi. Malawi, a country located in Southeast Africa, has one of the worlds highest rates of child marriages. Additionally, 20-30% of maternal deaths are because of teenage pregnancies, and girls are commonly married off before the age of 18. This has trapped the country in a poverty cycle because girls are not given the opportunity to go to school. Chief Theresa Kachindamoto has been the tribal leader of the Dedza District since 2003, and her goal has been to put a stop to child marriages. Theresa has annulled almost 2600 child marriages, and has sent the girls back to school. Theresa often receives death threats and hate from her community, but she continues to fight for young girls.

Keeping Up With The Kurrent Events Pt. 2 – Humanitarians of the World
The Humanitarian Society of Vancouver would like to recognize Greta Thunberg for her incredible work on bringing awareness to the climate change crisis. At the age of 15, she skipped school to protest in front of Sweden’s parliament building and was determined ever since to continue her protest until the government met the carbon emissions target agreed by the world leaders in 2015. She then went viral on social media which encouraged over 20,000 students around the world to also protest. In 2019, Greta took the school year off to continue campaigning for climate change. She has attended protests and has spoken at many conferences internationally. For instance, she had travelled to New York, by boat, to speak to world leaders at the UN Climate Action Summit. Although Greta has won many awards, she has been persistent throughout her career to see real change on this topic.

Series 3 – Black Excellence for Black History Month
Before the world discovered Rosa Parks, there was a girl named Claudette Colvin. In March 1955, Claudette got on the bus after school. Her teacher had just been talking about important Black figures in history, so Claudette was feeling inspired. She sat on the middle seat on the bus, and refused to move when a white woman asked her to change seats. The police handcuffed Claudette, took her off the bus and placed her in an adult jail. 9 months later, Rosa Parks did the same thing, she refused to move to the back of the bus. Claudette got to know Rosa very well later on, and she believes Rosa was chosen to be the face of the movement because she fit the profile, “the kind associated with middle class”. The National Association for the Advancement of Coloured People (NAACP) did not accept Claudette because she was young and later became pregnant. Let’s appreciate her efforts and help raise more awareness this Black History Month.

Series 3 – Black Excellence for Black History Month
This week we would like to acknowledge a Canadian couple, Joan and Rocky Jones, who played key roles in the 1960s Black rights movement. Rocky was a lawyer who fought for social justice for the Black and Indigenous community. Additionally, Joan was the brains behind many of the Jones’ successful work in the 60s. Joan and Rocky moved to Nova Scotia and noticed many issues the Black community had been facing. Throughout their lives, they focused on issues of police brutality, and employment and housing discrimination. Together, they founded Kwacha House which provided housing for impoverished youth. Kwacha Houses goal was to decrease incarceration and school drop/out rates. They were also able to bring the Black Panther Party to Halifax as well. Joan and Rocky spent their entire lives fighting for Black and Indigenous people. Even after their divorce, they never stopped fighting for equal rights. #RockyJones #JoanJonas #BlackHistoryMonth #BlackExcellence

Series 3 – Black Excellence for Black History Month
To end of Black History Month, the Humanitarian Society of Vancouver would like to recognize Jackie Robinson. In 1947, Jackie broke the baseball color barrier in America by starting at base for the Brooklyn Dodgers. Although having to experience severe forms of racist abuse with fans hurling bottles and invectives at him, teammates openly protesting against having to play with him, and players on opposing teams deliberately pitching balls at Robinson’s head, Jackie broke MLB’s colour barrier and set the state for the burgeoning civil rights movement. Robinson’s character, his use of nonviolence, and his talent challenged the traditional basis of segregation that had then marked many other aspects of American life. Even after retirement, he continued to advocate for minority groups by becoming a spokesperson for the National Association for the Advancement of Coloured People (NAACP). He was a vocal champion for African American athletes, civil rights and other social and political causes. #BlackHistoryMonth

Today we celebrate International Women’s Day to honour the cultural, political, and socioeconomic achievements of women; additionally, this day recognizes the women’s rights movement which brings awareness to gender equality. Take a moment out of your day to reflect and appreciate the women in your lives!

Series 4 – Women’s History Month
This week we would like to acknowledge The Famous Five: Henrietta Muir Edwards, Nellie McClung, Louise McKinney, Emily Murphy, and Irene Parlby. They fought for the recognition of women as ‘persons’ under the British North America Act.
In 1928, the Supreme Court ruled that women were not qualified as ‘persons.’
The Famous Five came together before the Supreme Court to on March 14, 1928 to fight for women’s status as ‘persons.’
On October 18, 1929, the judicial committee overruled the Supreme Court and held that women were “qualified persons” and eligible to be appointed to the Senate.

As emphasized through rigorous scientific review of available medical evidence by Health Canada, all COVID-19 vaccines in Canada are effective and safe. The best vaccine is the one available to you first. Currently, individuals aged 18+ in BC are able to register for their COVID-19 vaccination. The date for your appointment will vary depending on your age and vaccine supply. A reminder that Provincial Health Officer (PHO) orders and guidelines remain in place for everyone, even if they have received the vaccine. For more updates on COVID-19 registration and vaccinations, visit @governmentofbc

Today, on National Physician’s Day, we would like to honour all of the doctors for their incredible dedication and compassion. 🩺
This year, more than ever, we are reminded of their commitment to patients each and every day as well as their resilience through such unprecedented times.
Thank you for all you do!

The COVID-19 pandemic has had a profound impact on the mental health of people of all ages. Now, more than ever, it is critical to reduce the stigma around mental health struggles, because that stigma often prevents individuals from seeking help. Nearly 450 million people worldwide are currently living with a mental illness, yet nearly two thirds of people with a known mental illness never seek treatment. May is a time to raise awareness of those living with mental or behavioral health issues and to help reduce the stigma so many experience. Help us spread the word through awareness, support and advocacy activities! #MHAM #MentaHealthAwareness #MentalHealthMatters

Happy pride month! Let’s take this month to appreciate one another. Fun fact the modern global LGBTQ+ pride movement started as a protest and riot in response to police harassment and brutality towards LGBTQ+ people in New York City, centred around a police raid that took place on the Stonewall Inn on June 28th, 1969. It is for that reason that June is Pride Month. The first few marches drew only a few hundred people, but the Pride Parades today include hundreds of thousands 🏳️🌈

une is Amyotrophic Lateral Sclerosis (ALS) Awareness Month, a campaign to spread awareness of and raise funds for a cure for ALS.
There is no cure for ALS, and ALS is recognized as having multiple interacting genetic and environmental factors. Approximately 80% of people with ALS die within 2-5 years of being diagnosed.
To raise and spread awareness of ALS:
1. Stay informed – educate yourself on ALS, and read stories of those who have lived with it
2. Donate – alsbc.ca/donate/
3. Become an advocate – educate yourself on key votes and legislation so that you can write informed letters to your representatives – alsbc.ca/advocacy/the-time-is-now
4. Volunteer your time towards opportunities to provide caregiver support, and helping administrative and event-based needs

World Hepatitis Day is announced each year on July 28th with a new theme to raise awareness of viral hepatitis, an inflammation of the liver that causes severe liver disease and hepatocellular cancer.
This year’s theme is ‘Hep can’t wait.’ With a person dying every 30 seconds from a hepatitis related illness – even in the current COVID-19 crisis – we can’t wait to act on viral hepatitis.
To mark the day, WHO is hosting a Global talk show providing a platform for global, regional and national leaders, policy makers, communities and others to discuss the hepatitis response to reach elimination by 2030.

International Indigenous Peoples’ Day
Happy National #IndigenousPeoplesDay! 🎉🥳 It is a time for us to honour and celebrate the rich cultures and unique traditions of First Nations, Inuit & Métis. Today, and every day, we must stand up against racism, and commit to working together with Indigenous peoples to build a better future.

Pride Month
No matter who you choose to love or how you identify, we all deserve to be ourselves and live free from discrimination! #pridemonth

Physical Distancing
Physical distancing means keeping a distance of at least two metres from others at all times.
Everyone needs to practice physical distancing, even if you have:
– NO symptoms of COVID-19
– NO known risk of exposure
– Not travelled outside of Canada within the last 14 days.
Do your part to help reduce the spread of COVID-19.

Terry Fox Foundation
On this Day in History – June 28, 1981: Terry Fox passed away at the young age of 22. Canada – and the world – lost a hero. 39 years since his death, the Terry Fox Foundation has raised over $750 million globally for cancer research. Terry’s Marathon of Hope continues to inspire optimism & raise funds for cancer research. Please visit @TerryFoxFoundation to find out how you can help keep his dream alive. terryfox.org/ #TodayWeRemember#MarathonofHope

What is shared online can have real consequences in the real world.
Pause and think about what you’re about to share online.

We would like to wish everyone a happy and safe Halloween! Trick-or-treating can be done with a few differences made:
⭕️Trick-or-treat in a small social group under 6
⭕️If you are feeling sick or are self-isolating, turn off your porch light and stay home
⭕️Skip homes with their lights off
⭕️Avoid places where you might not be able to maintain physical distance
⭕️Include a mask in your costume
⭕️Wash or sanitize your hands before, during, and after trick-or-treating
⭕️Hand out treats carefully

It’s flu season, so get your flu shot today! Not only so you can protect yourself but also protect those around you. This way we can help lower the rates of flu hospitalization and continue to stay healthy. #FluSeason#NoTimeForFlu

Keeping Up With The Kurrent Events Series 2 – Crisis around the world🌏
250 million individuals, including the farmers of Punjab and Haryana, have been protesting in India after Modi’s government passed 3 controversial farm bills. A private marketing system threatens the removal of the minimum support price (MSP) that has been put in place for farmers for many years. The MSP guarantees a set price for produce, but now private corporations will ignore that price. These laws will put farmers in greater debt which will in turn ruin the livelihood of many families. Farmer suicide in India has been a huge issue for years, but these laws may be even more threatening. The Humanitarian Society of Vancouver stands in solidarity with these peaceful protesters and hopes the rights of individuals in India remain protected. #FarmBill2020 #IStandWithFarmers

Keeping Up With The Kurrent Events Series 4 – Crisis around the world🌏
There is a genocide happening against Uyghur Muslims in China right now. In 2015, China had began building facilities in a region known as Xinjiang, but the purposes of these buildings were unknown. Xinjiang is a region where 11 million Uyghur Muslims live, but it was too early for anyone to gain suspicion about the construction. In 2018, through satellite images, it became clear that many camps were built in Xinjiang. The government said these were “re-education camps” for Uyghurs; however, they are actually forms of internment camps built to strip Uyghurs of their religion and ethnic identity. The enslaved Muslims have faced physical abuse such as waterboarding and sleep deprivation. Women have faced sexual abuse and forced sterilization. The enslaved Muslims have also been forced into labour. 20% of the worlds cotton is forcibly produced by 570,000 Uyghur Muslims. This cotton is then used by the clothing industry; Therefore, the fashion industry benefits from the enslavement of Uyghur Muslims. There are about 83 brands that benefit from Uyghur forced labour such as Nike, Uniqlo, H&M, Zara, Victoria Secret and many more. #UyghurMuslims #StandWithUyghurs #FreeTheUyghurs

Keeping Up With The Kurrent Events Pt. 2 – Humanitarians of the World
The Humanitarian Society of Vancouver would like to recognize Ravi Singh, the founder of Khalsa Aid, for his incredible international humanitarian work. Ravi Singh established the NPO, Khalsa Aid, in 1999. A core value of Sikhism is selfless service which inspired Singh to start an international organization. Khalsa Aid has provided aid to victims of tragic events including war and natural disasters. Additionally, Singh has personally travelled around the world to assist people in need. Singh has been acknowledged for his amazing work by receiving awards. In 2014, Singh was presented with the Sikh of the Year award, followed by the International Sensation award in 2017. Recently Khalsa Aid was nominated for the Nobel Peace Prize by members of the Canadian Parliament.

As the farmers’ protest takes place in India, the world’s largest democracy, many domestic and international human rights have been violated by the Indian government and the Indian police force. The farmers have been peacefully protesting for months in India’s capital, Delhi, against the three farms bills passed by the BJP party. The bill includes laws such as privatization of agriculture and removal of Minimum Support Price which many small farmers are afraid will hurt them in long-run. The Indian government has used police brutality, water cannons, tear gas and road blockades such as concrete walls and barbed wires to suppress the protestors. They have cut off internet at protest sites around Delhi, have charged many activists and journals unlawfully, and also cut off protestors’ access to sanitation, food and water. These unlawful tactics have created a very hostile and unsafe environment for the protestors as they fight to raise their voices against the government. #IStandWithFarmers #FarmersProtest

Series 3 – Black Excellence for Black History Month
This week we would like to acknowledge a Canadian civil rights leader, Hugh Burnett. Burnett was a key figure in the fight for anti-discrimination legislation in Ontario. He worked alongside the National Unity Association (NUA) during the 1940s and 1950s. Although discrimination against BIPOC was common across Canada, it was very high in Dresden Ontario. Many business owners would refuse service to the Black community. In 1943, Burnett walked into a restaurant in his army uniform, but was denied service. After this incident, Burnett was determined to fight and later became the lead spokesperson for the NUA. As a result of Burnett’s and the NUA’s hard work, 2 important laws were passed that tackled discrimination: Fair Employment Practises Act and the Fair Accommodation Practises Act

Series 3 – Black Excellence for Black History Month
The Humanitarian Society of Vancouver would like to acknowledge Viola Desmond, who’s case inspired Nova Scotia’s civil rights movement. In November 1949, Viola decided to go to the Roseland Theatre not knowing it was segregated. She was given a balcony seat ticket even though she had paid extra for the main-seating area. After she confronted the cashier, Viola was told “I’m not permitted to sell downstairs tickets to you people”. Viola refused the balcony tickets and made her way to the main-seating area where only White individuals were allowed to sit. The police were called and Viola was dragged out of the theatre. She spent the night in jail after suffering some injuries from the police encounter. Although Viola was told to forget about the incident, she wanted to continue fighting. Through her determination the case made it to the Supreme Court of Canada; however, the courts were not on her side. Although the case was over, the fight to end segregation was not. Thanks to the efforts of Viola Desmond (and others like her) and the Nova Scotia Association for the Advancement of Coloured People (NSAACP), segregation in Nova Scotia was put to a stop in 1954.

Series 4 – Women’s History Month
In March we celebrate women’s history month to honour achievements made by women throughout history. Therefore, this week we would like to acknowledge Amelia Earhart who was the first woman to fly solo across the Atlantic Ocean. She was also known for encouraging women to reject constructive social norms and to pursue opportunities in aviation. She helped found an organization of female pilots known as the Ninety-Nines and served as its first president. In 1947, Amelia Earhart set out to fly around the world. Unfortunately on July 2, 1937, she mysteriously disappeared while flying over the Pacific Ocean.

Series 4 – Women’s History Month
This week we would like to acknowledge Malala Yousafzai who so bravely stood up for the education of girls even at the expense of her own life.
Malala was targeted by the Taliban and shot in the head for speaking out publicly on girls’ right to learn. She established Malala fund, a charity dedicated to giving every girl an opportunity to achieve a future she chooses. Malala often visits many countries to meet with girls fighting poverty, wars, child marriage, and discrimination to go to school.
In October 2014, at just 17 years old, Malala became the youngest person to receive the Nobel Peace Prize for her fight for the right of every child to receive an education.

Series 4 – Women’s History Month
This week we would like to acknowledge Marsha P. Johnson. The “P” in her name stood for “Pay it no mind” which is what Marsha said in response to questions about her gender.
She was a prominent figure in the Stonewall uprising of 1969. The stonewall riots were a series of spontaneous demonstrations by members of the gay community in response to a police raid in June 1969 at the Stonewall Inn in Manhattan, New York.
Many in the LGBTQ community give credit to Johnson for throwing the first brick or shot glass that sparked the riots, however, Marsha said she didn’t arrive at the bar until rioting was underway.

The Humanitarian Society of Vancouver would like to thank all of our volunteers for their contributions during this celebratory week! We sincerely appreciate the countless hours of work and support received from our volunteers. We aspire to continue providing opportunities for you all to take charge of new initiatives and to apply your knowledge/passions to address community issues. #NationalVolunteerWeek

What is happening in Palestine is settler colonialism, military occupation, land theft, and ethnic cleansing. This issue is one of humanitarian and universal concern.
During the month of Ramadan, Palestinians have been forcefully displaced from the Sheikh Jarrah neighbourhood by Israeli colonizers, violent attacks have been taking place at Al-Aqsa Mosque – a sacred place of worship, and there have been large casualties, mostly children, from the massive air strikes in Gaza by Israeli forces.
Swipe to learn more about what is going on between Israel and Palestine, and what we can do to help 🇵🇸 #SaveSheikhJarrah #FreePalestine #WeStandWithPalestine

Tk’emlúps te Secwépemc First Nation Chief Rosanne Casimir announced that a mass grave containing the remains of 215 children were found at a formal residential school in Kamloops, BC. Some children were as young as three years old.
These residential schools were set up to assimilate the Indigenous people, tearing them away from their heritage, communities, and way of life.
We are not talking about a distant history here – this school in Kamloops only closed in 1978. The last residential school closed in 1996.
As settlers who are not original to this land of Canada, we ALL have a responsibility to learn more about, advocate for, and restore the relationship with Indigenous Peoples.

Climate change includes both global warming driven by human induced emissions of greenhouse gases and the resulting of the large scale shifts in weather patterns. In fact the 20 warmest years on record have been in the last 22 years. Scientists are worried that the impacts of climate change could be irreversible by 2030, causing more than 1 million species at risk of extinction. Climate change is currently happening and progressively getting worse, which are also detrimental to human life, impacting human health. Many leaders are not taking this seriously and it’s time for change. Start small and go on from there to reduce climate change. We only have one home 🌎

After winning bronze in the 4x100m medley relay in Tokyo, Penny Oleksiak became Canada’s most decorated Olympian of all time, with 7 Olympic medals, and she’s only 21. No Canadian Olympian, summer or winter, has more Olympic medals than Penny Oleksiak’s 7!


Currently Afghanistan is going under a crisis, where thousands of Afghans are seeking refuge and shelter from the dangers the Taliban present in Afghanistan. It is said by the Taliban that they have changed, but many Afghans, disagree as multiple countries around the world are racing to figure out a way to help. Please take this time to find ways to donate that will help Afghani refugees.
Get new content delivered directly to your inbox.